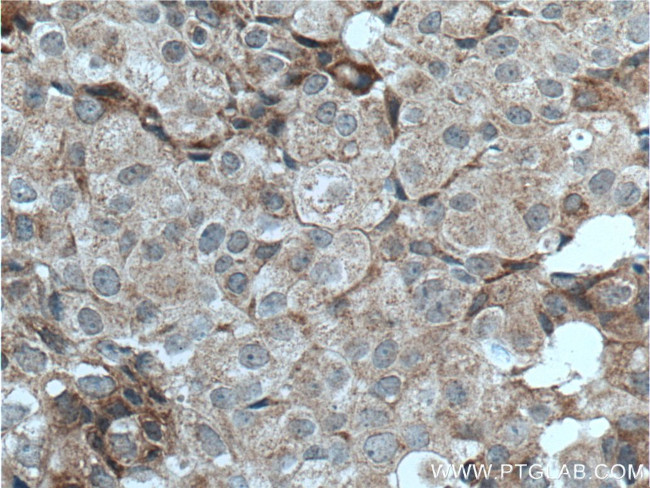
LTBP1 Antibody in Immunohistochemistry (Paraffin) (IHC (P))

Search
Proteintech
LTBP1 Polyclonal Antibody
{{$productOrderCtrl.translations['antibody.pdp.commerceCard.promotion.promotions']}}
{{$productOrderCtrl.translations['antibody.pdp.commerceCard.promotion.viewpromo']}}
{{$productOrderCtrl.translations['antibody.pdp.commerceCard.promotion.promocode']}}: {{promo.promoCode}} {{promo.promoTitle}} {{promo.promoDescription}}. {{$productOrderCtrl.translations['antibody.pdp.commerceCard.promotion.learnmore']}}
产品信息
22065-1-AP
种属反应
宿主/亚型
分类
类型
抗原
偶联物
形式
浓度
规格
纯化类型
保存液
内含物
保存条件
运输条件
产品详细信息
Immunogen sequence: VEALTFSRE HGPGVAEPEV ATAPPEKEIP SLDQEKTKLE PGQPQLSPGI STIHLHPQFP VVIEKTSPPV PVEVAPEAST SSASQVIAPT QVTEINECTV NPDICGAGHC INLPVRYTCI CYEGYRFSEQ QRKCVDIDEC TQVQHLCSQG RCENTEGSFL CICPAGFMAS EEGTNCIDVD ECLRPDVCGE GHCVNTVGAF RCEYCDSGYR MTQRGRCEDI DECLNPSTCP DEQCVNSPGS YQCVPCTEGF RGWNGQCLDV DECLEPNVCA NGDCSNLEGS YMCSCHKGYT RTPDHKHCRD IDECQQGNLC VNGQCKNTEG SFRCTCGQGY QLSAAKDQCE DIDECQHRHL C (455-804 aa encoded by BC130289)
靶标信息
The protein encoded by this gene belongs to the family of latent TGF-beta binding proteins. The secretion and activation of TGF-betas is regulated by their association with latency-associated proteins and with latent TGF-beta binding proteins. The product of this gene targets latent complexes of transforming growth factor beta to the extracellular matrix, where the latent cytokine is subsequently activated by several different mechanisms. Alternatively spliced transcript variants encoding different isoforms have been identified.
仅用于科研。不用于诊断过程。未经明确授权不得转售。
篇参考文献 (0)
生物信息学
蛋白别名: Latent-transforming growth factor beta-binding protein 1; LTBP-1; MGC163161; TGF-beta1-BP-1; Transforming growth factor beta-1-binding protein 1; transforming growth factor-beta 1 binding protein precursor; unnamed protein product
基因别名: ARCL2E; LTBP1
UniProt ID: (Human) Q14766
Entrez Gene ID: (Human) 4052